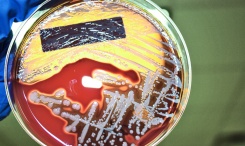

New molecular imaging approach could aid vast areas of health, disease
Matt O'Connor (Health Imaging)
http://www.healthimaging.com/topics/molecular-imaging/new-molecular-imaging-approach-could-aid-vast-areas-health-disease
A new multimodal imaging approach produced highly-advanced molecular three-dimensional (3D) images of staph infection and may be instrumental in fighting antibiotic resistant infections, according to research published online March 14 in Science Translational Medicine.
“I’m pretty convinced that these are the most advanced images in infection biology,” said corresponding author Eric Skaar, PhD, MPH, with the Department of Pathology, Microbiology and Immunology at Vanderbilt in a university news story.